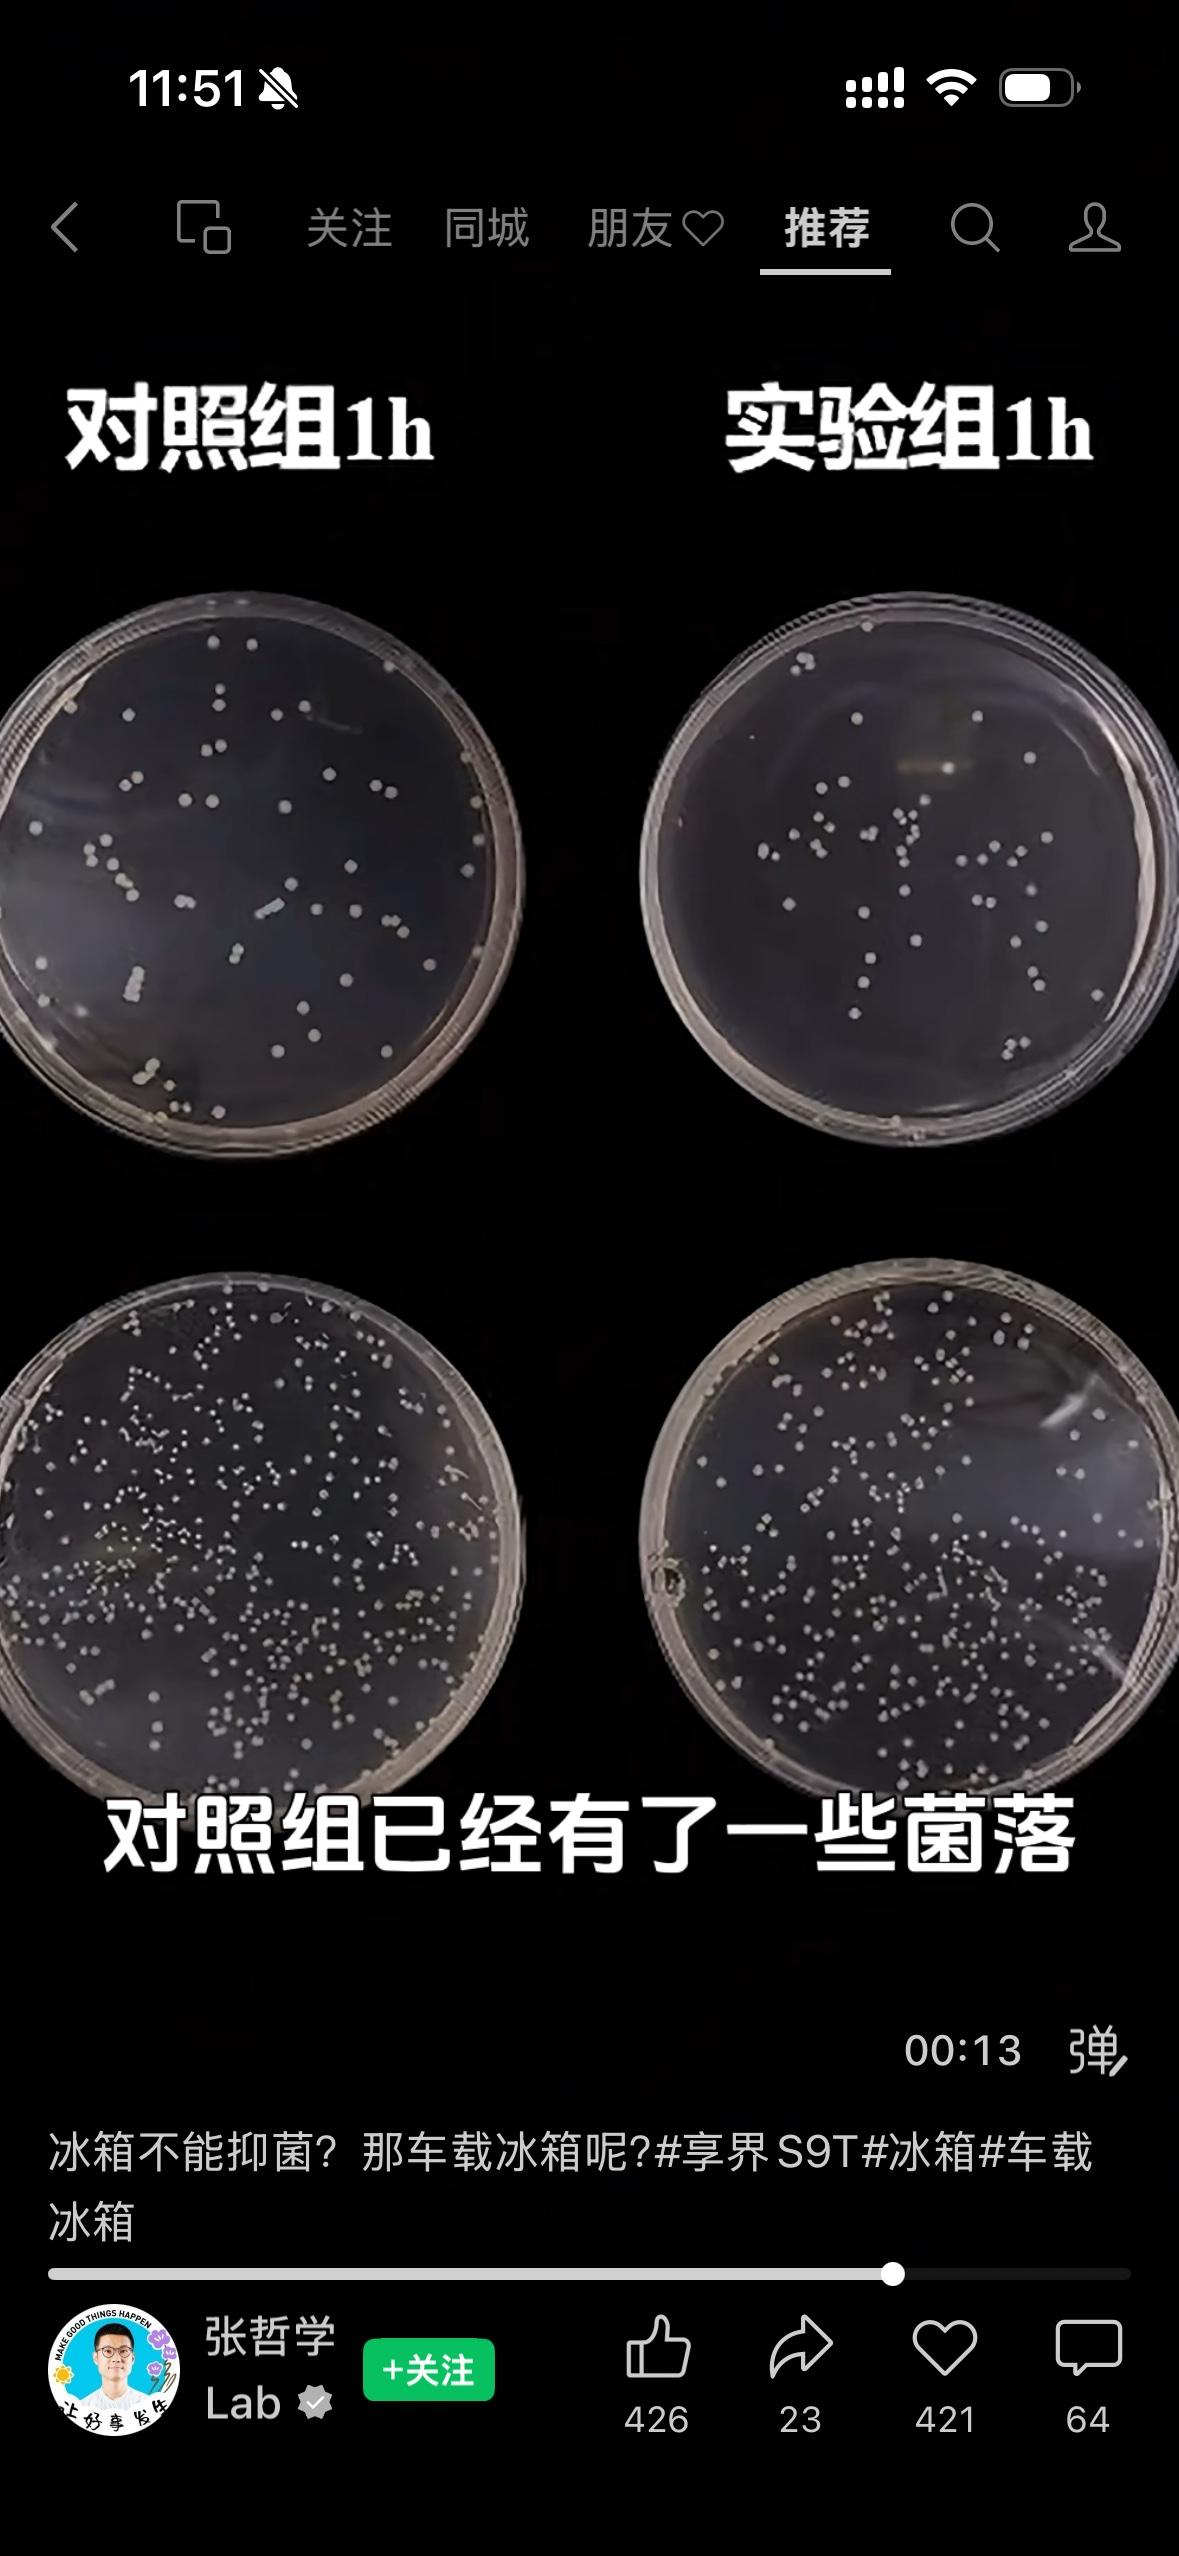

车载冰箱到底安不安全,看这个测试就够了,以前没有冰箱彩电大沙发的时候大家安全意识薄弱可以理解,但是如今车载冰箱都已经下探到十五万左右的价位区间,图片中的视频作者采用的是普通车载冰箱对比S9GT的车外冰箱,在针对单增李斯特氏菌株的实验中,S9GT对该病菌的抑制性表现不错,该病菌的危害⚠️可以看第二张图



车载冰箱到底安不安全,看这个测试就够了,以前没有冰箱彩电大沙发的时候大家安全意识薄弱可以理解,但是如今车载冰箱都已经下探到十五万左右的价位区间,图片中的视频作者采用的是普通车载冰箱对比S9GT的车外冰箱,在针对单增李斯特氏菌株的实验中,S9GT对该病菌的抑制性表现不错,该病菌的危害⚠️可以看第二张图

猜你喜欢
作者最新文章
热门分类
汽车TOP
汽车最新文章